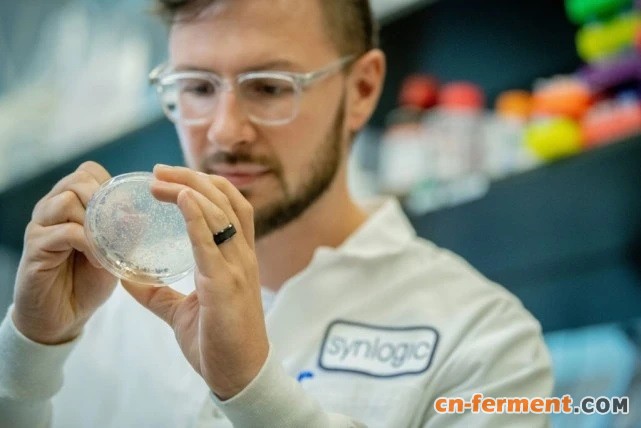
2

近年来,合成生物学领域的研究不断推进,许多公司纷纷出手,将合成生物学用于治疗各种各样的疾病,包括靶向微生物组。那么有哪些在微生物组领域探索的合成生物学公司呢?
今天,我们特别关注合成生物学在微生物组领域中的应用,希望本文能够为相关的产业人士和诸位读者带来一些启发与帮助。
合成生物学掀起的巨大变革
只需看看汉堡王新推出的“不可能汉堡”(使用植物性肉排,模拟真肉的口感),我们就可以看到合成生物学掀起的巨大变革。
除了食品生产以外,在许多其他领域中,合成生物学也使得那些原本不可能发生的事情成为现实。例如,合成生物学能够生产可再生燃料和制成品,并协助生物降解,这些应用都有助于维持地球的健康。那我们人类的健康呢?
合成生物学也正以各种各样的方式,来改善我们的健康,比如用以研发新疗法,在这些新疗法中,一些采取直接的方式,比如重建人体细胞的信号通路,而另一些则采用间接的方式,比如靶向我们的微生物组。
今天,我们特别关注微生物组领域的合成生物学公司。这些公司开发出了一些巧妙的方法,来靶向我们体内的细菌,从而解决健康问题。不论是通过对已有的细菌进行体内基因编辑,还是利用海藻传递改造后的细菌,这些公司都承诺:与现在的药物相比,未来的药物将看起来大不相同。

靶向微生物组的基因疗法
总部位于法国巴黎的 Eligo Bioscience 公司,在成长和发展的同时,也在寻找自己的定位。Eligo 公司成立于 2014 年,当时,人们视其为噬菌体公司或微生物组公司。
但现在,七年过去了,Eligo 公司已明确地向人们展示,它并不是上述这两类公司;相反,它是一家结合了基因编辑和微生物组的公司,而这一切都源于两位联合创始人的研究方向。
Luciano Marrafini 博士,是 CRISPR 技术的先驱,并且也是洛克菲勒大学细菌学实验室的负责人,Timothy Lu 博士是一位合成生物学专家,也是麻省理工学院生物工程、电气工程和计算机科学专业的副教授。
Eligo 公司的首席执行官 Xavier Duportet 博士,将 Eligo 公司与针对人体细胞基因的基因治疗公司类比(比如 Intellia Therapeutics 公司),但他们针对的是致病菌的基因,而不是人体细胞中的基因。为此,该公司将靶向人体细胞基因的体内基因编辑技术,应用于微生物组。
Duportet 指出,在过去的几年里,已经有多个例子证明,特定细菌基因的表达和某种疾病相关。因此,Eligo 公司将利用基于 CRISPR 的基因编辑体系,使那些被证实与疾病相关的细菌基因沉默。
Eligo 公司的药物——“Eligobiotics”,由一种病毒载体(由没有噬菌体基因组的噬菌体颗粒)组成,它包含基因编辑的有效片段,并且只针对目的细菌。一旦CRISPR体系构建成功,并被患者服用,这种基因编辑过程就会在体内、在肠道内发生,使目的基因沉默并摧毁细菌。
去年夏天,Eligo 公司与葛兰素史克公司(GlaxoSmithKline)合作开发了一款候选产品 EB005,它针对的是皮肤微生物组中的痤疮丙酸杆菌,这种细菌会引起痤疮。
Eligo 公司的另一个候选产品 EB003 将于明年进入I期试验。EB003 被开发用于治疗由产志贺毒素大肠杆菌(STEC)引起的严重腹泻。据 Eligo 公司称,今年早些时候公布的临床前数据,是有史以来第一次在相关疾病模型中证明,CRISPR 医疗手段对肠道疾病有影响。
最后,Eligo 公司也在研究耐药(AMR)菌,该项目由一个非盈利机构 CARB-X 支持。这个药物被命名为EB004,旨在去除器官移植受者肠道内细菌的 AMR 基因,以预防细菌感染。
Duportet 解释说,肠道内有 AMR 菌的移植患者,移植后有 50% 的几率会出现 AMR 菌感染。在感染的情况下,死亡率高达 70%。如果去除 AMR 菌,死亡率可降至 4%。EB004 将去除细菌中的AMR基因,从而使治疗成为可能。
图. Synlogic公司在开发用于PKU的药物(被称为Synthetic Biotics)方面取得了阳性的中期数据,这使得该公司也推进了其针对其他遗传和后天代谢适应症的项目。预计于2022年,Synlogic将提交一份新的研究药物申请,以研究Synthetic Biotics用于其他的代谢适应症。此外,该公司还计划针对其他类型的疾病展开研究,如实体瘤、炎症和免疫紊乱。
苯丙酮尿症的阳性数据
两种用于治疗苯丙酮尿症(PKU)的合成生物制剂的中期分析数据,于 2021 年 9 月底激起了热议。这两种候选产品中,研究较为靠前的是 SYNB1618,已在II期试验 SynPheny-1 研究中进行了评估。
Synlogic 公司的首席执行官 Aoife Brennan 博士说:“其他的一些口服产品,只对某些基因亚型的PKU患者有效。而我们的这些数据表明,SYNB1618 是首个口服、安全、有效、适用于所有基因型 PKU 患者的药物。”
SynPheny-1 研究首次表明,在 PKU 患者胃肠道中消耗肠道内的苯丙氨酸(Phe),可以有效降低全身血浆Phe水平。“这是首次,”Brennan 解释说,“利用工程菌(通过合成生物平台生产)的基于肠道的方法,在疾病活动的全身性检测中,显示出了临床相关的变化。”
这些数据表明,SYNB1618 可降低 PKU 患者的空腹 Phe 水平。在II期研究的中期分析中,该药物在多个时间点的多个剂量水平上,都显示出了具有临床意义的降低 Phe 水平的能力。
第二种 PKU 药物 SYNB1934,在包含健康志愿者的头对头 I 期研究中,显示出了高出 SYNB1618 两倍的活性。SYNB1934 是下一代优化菌株,其表达的苯丙氨酸解氨酶具有更强的活性。
这些未发表的科学数据将在即将召开的大会上公布。此外,他们还计划于明年获得最终的研究结果后,提交一份新的研究申请。基于新的数据,Synlogic 公司将把 SYN1934 与 SYNB1618 一起纳入下一步的试验。根据研究的最终结果,该公司将挑选其中一种推进到III期试验。
“第一次看到具有临床意义的终点数据的时候,那真是最美好的一天,”Brennan 说,“这个 PKU 项目验证了我们的假设,真是非常激动人心。”
该公司此前已经探究了该菌株在健康志愿者和 PKU 患者胃肠道中消耗 Phe 的机制,这是由菌株特异性生物标志物介导的。但这是第一个证明了消耗胃肠道内的 Phe,会降低血浆中的全身 Phe 的研究。这是非常有意义的,因为它表明,对 PKU 患者而言,Synlogic 公司的方法可能有着巨大的治疗益处。
Synologic 公司称其疗法为 Synthetic Biotics。该公司计划评估它们是否对其他代谢性疾病也有效。
例如,Synlogic 公司的 SYNB8802 已经显示出了治疗肠源性高草酸尿的潜力,在这种疾病中,草酸水平的异常升高可能会损害肾脏。SYNB8802 的临床前和 Ia 期研究表明,它具有在患者体内消耗具有临床意义量的膳食草酸的潜力。

图. Synologic 公司的科学家们对大肠杆菌 Nissle 进行编辑,将其用于治疗不同的疾病。PKU 药物研发项目是在大肠杆菌 Nissle 的基因组中,插入了一个编码苯丙氨酸解氨酶的细菌基因。苯丙氨酸解氨酶是一种在肠道内分解Phe的酶,它可以将 Phe 转化为反式肉桂酸。
合成生物学+海藻
Synlogic 公司并不是唯一一家致力于治疗肠源性高草酸尿的公司。这种疾病也引起了 Federation Bio 公司(成立于 2019 年)和 Novome Biotechnologies 公司(成立于 2016 年)的关注,它们都在致力于开发基于微生物组的药物,用于治疗肠源性高草酸尿。
Federation Bio 公司是一家微生物组公司,它设计的药物主要为细菌混合物(一粒药丸中最多含有 100 种细菌)。
而 Novome Biotechnologies 公司则采用了与 Synlogic 公司类似的方法,但这个方法可能更巧妙。Novome-001 是 Novome 公司针对肠源性高草酸尿的候选药物,去年夏天,该公司开始对其进行I期试验。根据 Novome 公司的说法,这是第一个在人类身上使用工程化定植的治疗方法。
当年的四名研究生共同创立了 Novome 公司,现如今他们已成为公司的领导人,他们是 Will DeLoache 博士(首席执行官)、Zachary Russ 博士(首席科学家)、Weston Whitaker 博士(研究副总裁)和 Liz Shepard 博士(人事主管)。
在研究生时代,DeLoache 和 Russ 在加州大学伯克利分校生物工程副教授 John Dueber 的实验室里一起工作。
Whitaker 也曾在 Dueber 实验室工作,后来去了斯坦福大学 Justin Sonnenburg 博士(微生物学和免疫学副教授)的实验室,进行博士后工作。也就是在那里,Whitaker 遇见了 Shepard。
与其他微生物组公司一样,Novome 公司的目标是设计细菌,使其在肠道内定植,从而发挥有助于治疗人类疾病的功能。然而,有两个特点使 Novome 公司与众不同。
首先是该公司的目标微生物。Novome 公司的目标细菌是拟杆菌(Bacteroides),这种菌是厌氧菌,在肠道微生物组中非常丰富,并且是一种常驻菌。而 Novome 公司的药物——一种拟杆菌产品,即使小剂量服用,也应该能在肠道内定植并增殖到治疗所需的数量。
但要对拟杆菌进行基因编辑,并不容易。迄今为止的研究表明,用于拟杆菌的基因编辑手段,比用于其他细菌的手段更难开发。因此,Novome 公司对拟杆菌做了大量的工作。
细菌药物在肠道内的定植能力是一把双刃剑。虽然,它可以减少对剂量的需求,但它也带来了一个挑战,即如何控制已经定植入肠道菌群的细菌量。因为拟杆菌作为肠道的常驻成员,需要对其生长增殖进行安全严格的控制。
Novome 公司的解决方案是海藻。更具体地说,Novome 公司的工程菌需要代谢卟啉,一种由海藻提供的多糖,并给工程菌的基因组中插入一个“处死开关”,使该菌株的生长依赖于海藻多糖。
DeLoache 声称,当卟啉作为药物的一部分被服用时,就可能可以控制患者体内的细菌数量。他声称,这个卟啉与细菌相结合的系统,可以避免菌株向未接受治疗个体的转移,也可以在结束治疗时将该菌株清除。
当然,这种多糖必须每天服用。如果剂量不足,工程菌将无法增殖,最终会消失。DeLoache 指出,该公司将会把拟杆菌和卟啉放在同一个胶囊中,以便每天一起服用。服用每日剂量的细菌,将确保工程菌定植于患者的肠道内,当然如果错过服用,将可能出现定植不成功。
在 Novome 公司制造的基因工程拟杆菌中,Novome 公司已经可以成功在其中插入分解毒素的酶途径的基因,或使其产生可被机体吸收的小分子,或分泌可在肠道局部输送的蛋白质。
更直接地说,Novome 公司的技术将蛋白质直接输送到肠道,这是一个极具挑战的任务。但这项技术同样也很有可能引起微生物组领域以外的公司的兴趣。例如,一些公司可能会利用 Novome 公司的技术,来促进药物输送到肠道。
3个“第一”
合成生物疗法的研发人员,在靶向微生物组候选药物方面,取得了 3 个“第一”:第一个在人体上进行评估的定植于肠道的治疗性工程菌;第一次证明利用靶向肠道的工程菌可引起疾病相关指标的全身性临床变化;第一种被证明对肠道疾病有影响的 CRISPR 药物。
这几个“第一”表明,合成生物学正在打破药物开发的障碍,并为将来更多的治疗“第一”铺平道路。
原文网址:
https://www.genengnews.com/topics/genome-editing/synthetic-biology/more-than-one-way-to-fight-disease-with-synbio-drugs/
作者|Julianna LeMieux
编译|Jessica





















































